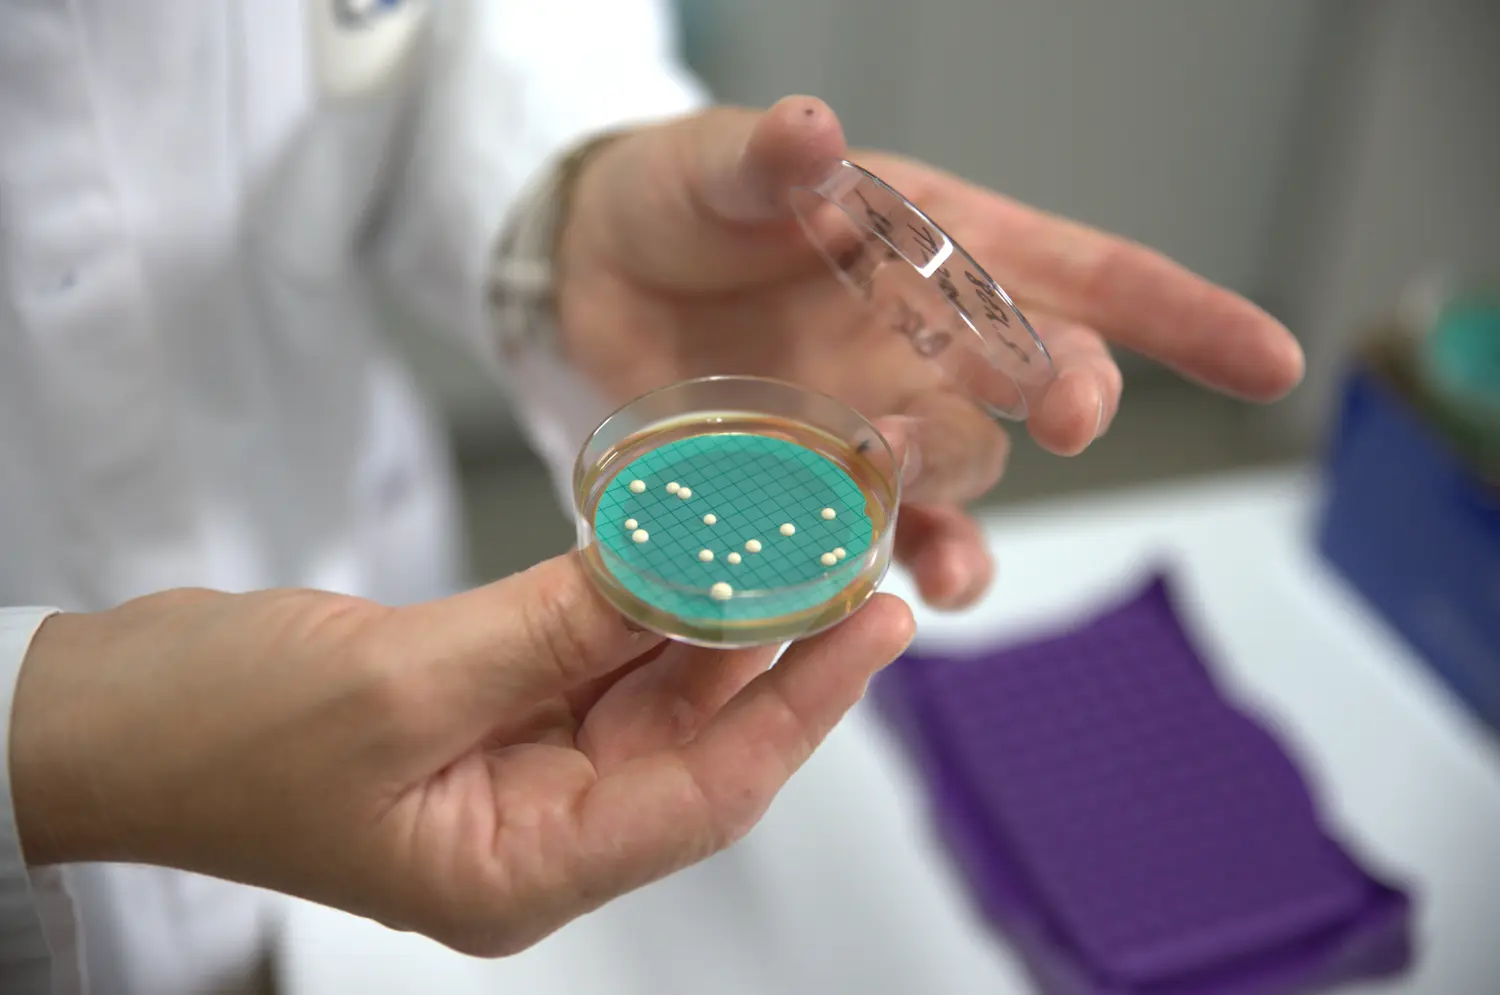
Microbiologie du vin - 2ème image d'illustration

Analyses microbiologiques

Microbiologie du vin
A quoi sert l’analyse microbiologique ?
Contrôler les populations de micro-organismes permet d’éviter leur développement et de mieux maîtriser la qualité de vos vins. Notre offre de service en microbiologie, associant le conseil œnologique à des techniques analytiques éprouvées, répond à vos besoins tout au long de d’élaboration du vin.
Les applications sont très nombreuses et ce type d’analyse répond à toute une variété de problématiques :
- Arrêt fermentaire : diagnostic et solutions
- Potentiel fermentaire : évaluation de la population d’un moût avant fermentation
- Evaluation de la population d’un levain
- Evaluation de l’aptitude du vin à réaliser spontanément la fermentation malolactique après fermentation alcoolique
- Estimation de la charge microbiologique :
- pour évaluer le risque de développement et le potentiel d’altération
- pour vous aider au choix du meilleur niveau de filtration/média filtrant
- Diagnostic Brettanomyces pour vos achats de vins ou les élevages en cuve ou barriques
- Enrayer rapidement les montées en volatile
